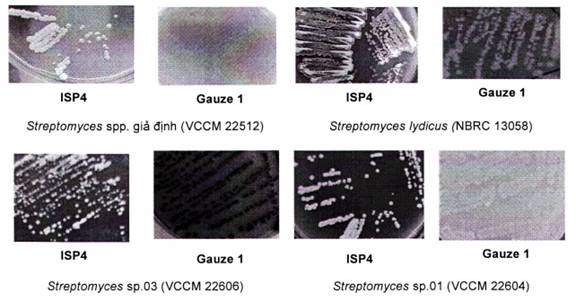

- Tổng quan
- Nội dung
- Tiêu chuẩn liên quan
- Lược đồ
- Tải về
Tiêu chuẩn quốc gia TCVN 14216:2024 Phân bón - Định lượng Streptomyces spp. Bằng kỹ thuật đếm khuẩn lạc
| Số hiệu: | TCVN 14216:2024 | Loại văn bản: | Tiêu chuẩn Việt Nam |
| Cơ quan ban hành: | Bộ Khoa học và Công nghệ | Lĩnh vực: | Nông nghiệp-Lâm nghiệp |
|
Ngày ban hành:
Ngày ban hành là ngày, tháng, năm văn bản được thông qua hoặc ký ban hành.
|
31/12/2024 |
Hiệu lực:
|
Đã biết
|
| Người ký: | Đang cập nhật |
Tình trạng hiệu lực:
Cho biết trạng thái hiệu lực của văn bản đang tra cứu: Chưa áp dụng, Còn hiệu lực, Hết hiệu lực, Hết hiệu lực 1 phần; Đã sửa đổi, Đính chính hay Không còn phù hợp,...
|
Đã biết
|
TÓM TẮT TIÊU CHUẨN VIỆT NAM TCVN 14216:2024
Nội dung tóm tắt đang được cập nhật, Quý khách vui lòng quay lại sau!
Tải tiêu chuẩn Việt Nam TCVN 14216:2024
TIÊU CHUẨN QUỐC GIA
TCVN 14216:2024
PHÂN BÓN - ĐỊNH LƯỢNG Streptomyces spp. BẰNG KỸ THUẬT ĐẾM KHUẨN LẠC
Fertilizers - Enumeration of Streptomyces spp. by colony-count method
Lời nói đầu
TCVN 14216:2024 do Viện Công nghệ sinh học - Viện Hàn lâm khoa học và Công nghệ Việt Nam biên soạn, Bộ Nông nghiệp và Phát triển Nông thôn đề nghị, Tổng cục Tiêu chuẩn Đo lường Chất lượng thẩm định, Bộ Khoa học và Công nghệ công bố.
PHÂN BÓN - ĐỊNH LƯỢNG Streptomyces spp. BẰNG KỸ THUẬT ĐẾM KHUẨN LẠC
Fertilizers - Enumeration of Streptomyces spp. by colony-count method
1 Phạm vi áp dụng
Tiêu chuẩn này áp dụng cho các loại phân bón, phân bón vi sinh có chứa Streptomyces spp. Trong đó, phát hiện Streptomyces spp. có hình thái, đặc điểm sinh lý trên môi trường thạch Gauze 1 (hoặc ISP4); định lượng Streptomyces spp. bằng kỹ thuật đếm khuẩn lạc trên môi trường thạch; định tính Streptomyces spp. bằng kỹ thuật giải trình tự vùng 16S rRNA được khuếch đại bằng cặp mồi 27F và 1495R.
2 Tài liệu viện dẫn
Các tài liệu viện dẫn sau là rất cần thiết cho việc áp dụng tiêu chuẩn. Đối với các tài liệu viện dẫn ghi năm công bố thì áp dụng phiên bản được nêu. Đối với các tài liệu viện dẫn không ghi năm công bố thì áp dụng phiên bản mới nhất, bao gồm cả các sửa đổi, bổ sung (nếu có).
TCVN 4884: 2005 (ISO 4833:2003): Thực phẩm, thực phẩm chức năng, thực phẩm bổ sung và thức ăn chăn nuôi. Định lượng vi sinh vật trên đĩa thạch kỹ thuật đếm khuẩn lạc ở 30 °C.
TCVN 6404:2016 (ISO 7218:2007). Vi sinh vật trong thực phẩm và thức ăn chăn nuôi - Yêu cầu chung và hướng dẫn kiểm tra vi sinh vật.
TCVN 7715-2:2007 (ISO 10272-2:2006), Vi sinh vật trong thực phẩm và thức ăn chăn nuôi. Phương pháp phát hiện và định lượng Campylobacter spp. Phần 2: Kỹ thuật đếm khuẩn lạc.
TCVN 8128:2015 (ISO 11133:2014). Vi sinh vật trong thực phẩm, thức ăn chăn nuôi và nước - Chuẩn bị, sản xuất, bảo quản và thử hiệu năng của môi trường nuôi cấy.
TCVN 12105:2018. Phân bón vi sinh vật - Lấy mẫu.
3 Thuật ngữ và định nghĩa
Trong tiêu chuẩn này áp dụng các thuật ngữ, định nghĩa sau đây:
3.1
Streptomyces spp.
Streptomyces spp là nhóm vi sinh vật sống hiếu khí, thường có trong đất ở vùng rễ cây trồng; có khả năng phân giải Cellulose và/hoặc đối kháng vi khuẩn/nấm gây bệnh cây trồng. Vi sinh vật này hình thành khuẩn lạc đặc trưng trên hệ thống môi trường ISP; có đặc điểm cuống sinh bào tử và bào tử được mô tả khi tiến hành các thử nghiệm theo tiêu chuẩn này.
3.2
Streptomyces spp. giả định (Putative Streptomyces spp.)
Streptomyces spp. giả định là những xạ khuẩn có khuẩn lạc mang các đặc điểm hình thái điển hình của Streptomyces spp. nhưng chưa được đánh giá thông qua phép thử khẳng định.
3.3
Định lượng Streptomyces spp. (Enumeration of Streptomyces spp.)
Phương pháp xác định đơn vị hình thành khuẩn lạc Streptomyces spp. (CFU/g hoặc CFU/ml) trong một đơn vị khối lượng hoặc thể tích cụ thể của phân bón, phân bón vi sinh, nguyên liệu sản xuất phân bón khi tiến hành các thử nghiệm theo tiêu chuẩn này.
3.4
Định tính Streptomyces spp. (Detection of Streptomyces spp.)
Phương pháp xác định sự có mặt hay không của Streptomyces spp. trong phân bón, phân bón vi sinh, nguyên liệu sản xuất phân bón bằng kỹ thuật giải trình tự vùng 16S rRNA khi tiến hành các thử nghiệm theo tiêu chuẩn này.
4 Nguyên tắc
Định lượng Streptomyces spp. trong phân bón, phân bón vi sinh, nguyên liệu sản xuất phân bón bằng phương pháp đếm số lượng đơn vị khuẩn lạc có hình thái đặc trưng, phát triển trên môi trường thạch Gause 1 sau 3-5 ngày nuôi cấy ở 28 ± 1°C. và được khẳng định thông qua đặc điểm cuống sinh bào tử dưới kính hiển vi quang học.
Định tính Streptomyces spp. trong phân bón, phân bón vi sinh, nguyên liệu sản xuất phân bón thông qua phương pháp giải trình tự gen.
5 Thiết bị, dụng cụ
Có thể sử dụng các dụng cụ dùng một lần thay cho các dụng cụ sử dụng nhiều lần nếu các thông số kỹ thuật tương tự.
Sử dụng các thiết bị, dụng cụ dùng trong thử nghiệm vi sinh thông thường được quy định trong TCVN 6404:2016 (ISO 7218:2007) và cụ thể như sau:
5.1 Thiết bị
5.1.1 Tủ cấy vi sinh vật, đảm bảo độ vô trùng.
5.1.2 Nồi hấp áp lực, có nhiệt độ hơi nước bão hòa trong buồng có khả năng duy trì nhiệt độ ở 121 °C ± 3 °C tương ứng áp suất tối thiểu 101,3 kPa.
5.1.3 Tủ sấy, thông gió đối lưu, có dải nhiệt độ từ 160 °C đến 180 °C, độ chính xác đến 1 °C.
5.1.4 Tủ ấm, thông gió đối lưu, có thể duy trì ở nhiệt độ từ 25 °C đến 35 °C, độ chính xác đến 1 °C.
5.1.5 Máy lắc, tốc độ đạt 200 r/min.
5.1.6 Cân phân tích, có độ chính xác đến 0,001 g.
5.1.7 Máy trộn Vortex, tốc độ lắc đạt 1000 r/min, lắc tròn.
5.1.8 Kính hiển vi quang học, có độ phóng đại đến 1 000x, sử dụng vật kính soi dầu.
5.1.9 Máy đo pH, có độ chính xác đến ± 0,1 đơn vị pH ở 25 °C.
5.1.10 Máy PCR, cho phép thể tích mẫu 10 ~ 100 μl.
5.1.11 Bể ổn nhiệt, có thể duy trì ở nhiệt độ từ 25 °C đến 90 °C
5.1.12 Máy khuấy từ gia nhiệt, có tốc độ khuấy từ 0 đến 1500 r/min và nhiệt độ dao động 0-100 °C
5.1.13 Máy soi ADN, có công suất tới 15W, điện áp tới 12V- 2A, bước sóng 470nm
5.1.14 Máy chụp ảnh thông thường
5.1.15 Bể điện di ngang, kích thước tùy điều kiện phòng thí nghiệm, có thể điều chỉnh cường độ dòng điện và thời gian.
5.1.16 Máy ly tâm, có tốc độ cao lên tới 14000 r/min có thể duy trì ở nhiệt độ từ 4 °C đến 30 °C
5.1.17 Máy NanoDrop, đo nồng độ ADN
5.1.18 Lò vi sóng thông thường
5.2 Dụng cụ
5.2.1 Bình tam giác, thủy tinh có dung tích 250 ml, 500 ml.
5.2.2 Cốc thủy tinh, có dung tích 100 ml, 250ml.
5.2.3 Ống nghiệm, có dung tích 16 × 160 mm.
5.2.4 Que cấy vòng, đầu que cấy bằng chất liệu Volfram.
5.2.5 Que dàn mẫu, bằng thủy tinh hoặc bằng chất dẻo hoặc bằng thép.
5.2.6 Pipets, có dung tích danh định 10 ml, 1 ml, 0,1 ml, 0,01 ml; sử dụng đầu tip vô trùng.
5.2.7 Đĩa Petri, đường kính 90 mm.
5.2.8 Lam kính, bằng thủy tinh.
5.2.9 Lamen, bằng thủy tinh.
5.2.10 Bông, không thấm nước.
5.2.11 Panh, bằng thép.
5.2.12 Ống eppendorf, có thể tích 0,5 ml, 1,5 ml, 2 ml.
6 Môi trường, hóa chất
6.1 Yêu cầu chung
Trong tiêu chuẩn này, chỉ sử dụng các loại hoá chất đạt cấp tỉnh khiết phân tích. Nước sử dụng phải là nước cất vô trùng hoặc có chất lượng tương đương quy định trong TCVN 8128:2015 (ISO 11133:2014).
Lưu ý: Ưu tiên sử dụng các thành phần cơ bản dạng khô, hoặc các môi trường hoàn chỉnh dạng khô để chuẩn bị môi trường nuôi cấy; thực hiện theo hướng dẫn của nhà sản xuất.
6.2 Nguyên lý chung khi pha môi trường thạch Gauze 1 và ISP4
Cân và hòa tan các thành phần trong nước cất theo thứ tự đã liệt kê trong các công thức môi trường (xem phụ lục A) đun nóng (nếu cần). Điều chỉnh pH về 7,0 ± 0,2 ở nhiệt độ phòng bằng dung dịch HCl 1M (36,45 g HCl trong 1 L nước cất) và NaOH 3 M (120 g NaOH trong 1 L nước cất). Phân phối hỗn hợp với lượng thích hợp vào các bình thủy tinh (5.2.1). Không vặn chặt nắp bình, khử trùng 15 min, trong nồi hấp áp lực (5.1.2) ở 121 °C.
Sau khi khử trùng môi trường được làm nguội đến 45 °C - 50 °C. Phân phối lượng khoảng từ 18 ml đến 20 ml môi trường vào các đĩa Petri (5.2.7) đã được chuẩn bị như nêu tại 8.1.1 và để cho đông đặc. Các thao tác được tiến hành trong tủ cấy vô trùng (5.1.1);
Khi môi trường đã đông đặc, làm khô bề mặt thạch trước khi sử dụng (đảm bảo không có các giọt nước trên bề mặt môi trường) bằng cách lật úp các đĩa thạch và để trong tủ ấm (5.1.4) ở nhiệt độ từ 25 °C đến 35 °C trong 25 min đến 30 min hoặc để qua đêm ở nhiệt độ phòng. Các đĩa môi trường sau đó sử dụng ngay hoặc bảo quản 4 °C trong vòng 1 tuần.
6.3 Dung dịch muối vi lượng
6.3.1 Thành phần
| Mangan clorua ngậm 4 phân tử nước (MnCl2.4H2O) | 0,1 g |
| Sắt sun phát ngậm 7 phân tử nước (FeSO4.7H2O) | 0,1 g |
| Kẽm sun phát ngậm 7 phân tử nước (ZnSO4. 7H2O) | 0,1 g |
| Nước cất bổ sung đạt thể tích | 100 ml |
| pH | 7,0 ± 0,2 |
6.3.2 Chuẩn bị
Cân và hòa tan lần lượt các thành phần trong nước cất theo thứ tự đã liệt kê (6.3.1), đun nóng nếu cần. Điều chỉnh pH về 7,0 ± 0,2 ở nhiệt độ phòng bằng dung dịch HCl 1M (36,45 g HCl trong 1 L nước cất) và NaOH 3 M (120 g NaOH trong 1 L nước cất). Lắc đều dung dịch trước khi phân phối vào các môi trường cần sử dụng.
6.4 Chuẩn bị dung dịch pha loãng
6.4.1 Thành Phần
| Natri clorua (NaCl) | 8,5 g |
| Nước cất bổ sung đạt thể tích | 100 ml |
| pH | 7,0 ± 0,2 |
6.4.2 Chuẩn bị
Cân và hòa tan các thành phần trong nước cất theo thứ tự đã liệt kê (6.12.1). Phân phối dung dịch pha loãng với lượng cần thiết để chuẩn bị các dung dịch pha loãng thập phân vào các ống nghiệm (5.2.3) sao cho sau khi khử trùng trong mỗi ống nghiệm chứa 9,0 ml. Sai số cho phép đo của thể tích cuối cùng sau khi khử trùng không được vượt quá ± 0,2 %;
6.5 Agarose 1 %
6.5.1 Thành phần
| Agarose | 1 g |
| Dung dịch đệmTAE 1X (Pha từ dung dịch gốc 50X) | 100 ml |
| Thành phần dung dịch gốc 50X: |
|
| Tris base (C4H11NO3) | 242 g |
| Acid acetic (CH3COOH) | 55,1 ml |
| Ethylendiamin Tetraacetic Acid (Na2EDTA) | 37,2 g |
| Nước cất bổ sung đạt thể tích | 1 lít |
6.5.2 Chuẩn bị
Cân và hòa tan các thành phần trong dung dịch đệm TAE 1X theo thứ tự đã liệt kê (6.13.1), đun nóng trong lò vi sóng (công suất trung bình) cho đến khi agarose hòa tan hết và dung dịch ở trạng thái trong suốt. Sai số cho phép đo của thể tích cuối cùng sau khi sử dụng không được vượt quá ± 0,2 %;
6.6 Hóa chất tách chiết ADN, PCR
Các hóa chất sử dụng trong quy trình tách chiết AND là những hóa chất tinh khiết của các hãng uy tín trên thị trường như Thermo, Biobasic, Sigma... hoặc các loại kít chiết tách khác nhau được cung cấp trên thị trường. Do đó, tùy thuộc vào điều kiện thực tế của phòng thí nghiệm để lựa chọn.
6.6.1 Thành phần đệm tách chiết ADN (đệm CTAB)
| Cetyltrimethylammonium bromide (CTAB) | 0,5 g |
| Ethylenediaminetetraacetic acid (EDTA) | 1,0 g |
| Tris (hydroxymethyl) aminomethane (Tris base) | 2,5 g |
| NaCl | 5,0 g |
| Nước cất | 100 mL |
6.6.2 Chuẩn bị
Cân và hòa tan các thành phần đã liệt kê (6.5.1). Phân phối hỗn hợp với lượng thích hợp vào các bình thủy tinh (5.2.1). Không vặn chặt nắp bình thủy tinh. Khử trùng 15 min, trong nồi hấp áp lực (5.1.2) ở 121 °C và và bảo quản ở nhiệt độ phòng.
6.6.3 Các hoá chất khác
- Lysozyme
- Chloroform, Isopropanol
- SDS 10 %
- Proteinaise K
- NaCl 5M
- Phenol/Cloroform/isoamylalcohol
- Isopropanol
- Ethanol 70 %
- Đệm TE (10 mM Tris-HCl; 1 mM EDTA)
- Loading dye
- Master Mix
*Sử dụng các bộ kít tách chiết ADN thương mại phù hợp với điều kiện thực tế của phòng thử nghiệm và thực hiện theo hướng dẫn của nhà sản xuất.
6.7 Mồi PCR
Cặp mồi khuếch đại đoạn gen 16S rRNA gồm: mồi 27F và 1495R
27F: 5’-GAG AGT TTG ATC CTG GCT CAG-3’
1495R: 5’-CTA CGG CTA CCT TGT TAC GA-3'
7 Lấy mẫu
Lấy mẫu theo TCVN 12105:2018.
Mẫu gửi đến phòng thử nghiệm phải là mẫu đại diện và không bị hư hỏng hoặc biến đổi trong suốt quá trình vận chuyển và bảo quản.
8 Cách tiến hành
8.1 Chuẩn bị
8.1.1 Dụng cụ
Các dụng cụ sử dụng trong nuôi cấy vi sinh vật phải được khử trùng bằng 1 trong 2 cách sau:
- Tiệt trùng khô ở nhiệt độ (170 ± 10) °C không ít hơn 1 h trong tủ sấy (5.1.3) hoặc;
- Tiệt trùng hơi nước ở nhiệt độ (121 ± 3) °C không ít hơn 15 min trong nồi hấp áp lực (5.1.2).
8.1.2 Chuẩn bị mẫu
Dùng cân phân tích (5.1.6) cân 10 g mẫu (dạng rắn) hoặc dùng pipet với đầu tip vô trùng (5.2.6) hút 10 ml mẫu (dạng lỏng) cho vào bình thủy tinh (5.2.1) chứa 90 ml dung dịch pha loãng đã chuẩn bị (6.5). Lắc trên máy lắc (5.1.5) từ 5 min đến 10 min sao cho vi sinh vật phân bố đồng đều trong dung dịch. Để cho các phần tử nặng lắng xuống trong thời gian không nhiều hơn 3 min, nếu cần. Dung dịch phía trên được gọi là dung dịch huyền phù ban đầu;
Dùng pipet với đầu tip vô trùng (5.2.6) hút 1 ml dịch huyền phù ban đầu cho vào ống nghiệm (5.2.3) chứa 9 ml dung dịch pha loãng đã chuẩn bị (6.5). Tránh chạm đầu tip vào dung dịch pha loãng. Trộn kỹ trên máy trộn Vortex (5.1.7) từ 5 s đến 10 s để có dung dịch mẫu độ pha loãng 10-2. Lặp lại qui trình để thu được dung dịch mẫu ở các độ pha loãng thập phân tiếp theo 10-3, 10-4, 10-5. Thường sử dụng độ pha loãng 10-5, 10-6, 10-7 đối với phân bón vi sinh.
Sử dụng chủng xạ khuẩn Streptomyces spp (VCCM 22512, VCCM 22604, VCCM 22606, NBRC 13058... hoặc các chủng chuẩn khác từ các Bảo tàng giống chuẩn trên Thế giới) được đăng ký lưu giữ tại Trung tâm giống và bảo tồn nguồn gen vi sinh vật, Viện Công nghệ sinh học, Viện Hàn lâm khoa học và Công nghệ Việt Nam, số 18 Hoàng Quốc Việt, cầu Giấy, Hà Nội, Việt Nam.
CHÚ THÍCH 1: Hoạt hóa mẫu (nếu có) theo hướng dẫn của nhà sản xuất để đảm bảo kết quả chính xác.
8.2 Cấy và ủ
Chỉ được sử dụng đĩa chứa môi trường Gauze 1 đã chuẩn bị (6.2) không bị tạp nhiễm.
Dùng pipet với đầu tip vô trùng (5.2.6) lấy 0,1 ml dung dịch mẫu cho vào mỗi đĩa Petri chứa môi trường phân lập đã chuẩn bị (6.2). Lặp lại qui trình với các dung dịch mẫu ở các nồng độ pha loãng thập phân tiếp theo; mỗi nồng độ thực hiện 2 đĩa Petri;
Dùng que dàn mẫu (5.2.5) dàn đều dịch cấy trên bề mặt đĩa thạch càng nhanh càng tốt mà không chạm vào thành đĩa Petri. Sử dụng một que dàn mẫu vô trùng cho mỗi đĩa Petri. Đậy nắp đĩa Petri và để yên trong khoảng 15 min ở nhiệt độ phòng.
Nuôi trong tủ ẩm (5.1.4) ở (28 ± 1) °C trong 3 ngày đến 5 ngày.
8.3 Đếm khuẩn lạc
Đếm các khuẩn lạc Streptomyces spp. giả định ở hai độ pha loãng liên tiếp, trên các đĩa Petri có chứa không ít hơn 15 khuẩn lạc và không nhiều hơn 300 khuẩn lạc theo TCVN 4884: 2005,
Trên môi trường Gauze 1, khuẩn lạc Streptomyces spp. giả định có hình dạng đặc trưng khô, xốp của chi Streptomyces, D = 3 - 5 mm sau 5 ngày (xem Phụ lục B). Dùng que cấy chạm nhẹ vào mép khuẩn lạc, cấy ria trên môi trường ISP4 vài lần nếu cần (Streptomyces sinh trưởng tốt hơn trên ISP4) để làm thuần chủng khuẩn trước khi thực hiện phép thử khẳng định.
Khuẩn lạc Streptomyces spp. giả định được khẳng định thông qua kiểm định hình thái cuống sinh bào tử dưới kính hiển vi quang học và giải trình tự gen rRNA 16S.
8.4 Khẳng định
8.4.1 Kiểm định hình thái tế bào
Tiến hành kiểm tra ít nhất 5 khuẩn lạc giả định để thực hiện phép thử khẳng định (Bước này thực hiện song song với bước (8.3)). Nếu trên đĩa Petri có ít hơn 5 khuẩn lạc thì lấy tất cả các khuẩn lạc có mặt;
Bước 1: Chuẩn bị đĩa Petri, lam kính, lamen, panh, bông ẩm (5), môi trường ISP4/Gauze 1 (6.2) và được hấp vô trùng (5.1.2).
Bước 2: Đặt bống và lam kính vào đĩa Petri.
Bước 3: Đổ môi trường ISP4/Gauze 1 vào một đĩa Petri khác để tạo môi trường lớp mỏng 0,5 mm. Sau đó, cắt thành các miếng 1x1 cm, đặt lên trên lam kính.
Bước 4: Chấm điểm các chủng vi sinh vật lên cạnh của các mảnh môi trường, đặt lamen lên trên bề mặt môi trường.
Bước 5: Nuôi trong tủ ấm (5.1.4) ở (28 ± 1) °C trong khoảng 3 đến 5 ngày
Quan sát cuống sinh bào tử của chủng vi sinh vật bằng kính hiển vi quang học ở độ phóng đại 100 lần (5.1.8), đánh giá đặc điểm khuẩn lạc, bào tử Streptomyces spp. (xem Phụ lục C);
8.4.2 Giải trình tự gen 16S rRNA
Chủng Streptomyces spp giả định được khẳng định thông qua kiểm định hình thái tế bào (8.4.1) được lấy bằng que cấy tiệt trùng (5.2.4) hòa trong 1500 μl nước muối sinh lý đã tiệt trùng trong ống eppendort 2 ml (5.2.12). Vortex mạnh để trộn đều sinh khối. Thực hiện các bước (xem phụ lục D) và sử dụng cặp mồi khuếch đại đoạn gen 16S rRNA (6.7).
Dữ liệu giải trình tự sau đó được phân tích bằng phần mềm Chromas phiên bản 2.4. Trình tự tinh chỉnh của từng phân đoạn được so sánh với trình tự 16S rRNA của các loài tương tự đã được công bố trong cơ sở dữ liệu của trình tự GenBank bằng công cụ tìm kiếm BLAST (xem phụ lục D). Giá trị tương đồng ≥ 98% của trình tự rRNA được coi là ngưỡng để khẳng định đến chi.
9 Tính và biểu thị kết quả
► Cách tính mật độ Streptomyces spp. được thực hiện theo TCVN 7715-2:2007
► Số khuẩn lạc Streptomyces spp. giả định được tính là số khuẩn lạc trong đĩa nuôi cấy mang các đặc điểm đặc trưng của Streptomyces spp. (8.3, phụ lục B)
► Số lượng Streptomyces spp. trong một đơn vị kiểm tra được tính bằng đơn vị hình thành khuẩn lạc (CFU) trên gram hay mililit, theo công thức (1):
|
| (1) |
► Trong đó:
+ N là số khuẩn lạc Streptomyces spp. trong một đơn vị kiểm tra, được tính bằng đơn vị hình thành khuẩn lạc ở dạng lỏng trong 1 ml (CFU/ml), hoặc dạng rắn trong 1 g (CFU/g);
+ ∑a là tổng số khuẩn lạc Streptomyces spp. giả định đếm được trên tất cả các đĩa Petri được giữ lại ở hai độ pha loãng liên tiếp, chỉ tính các đĩa có chứa không ít hơn 15 khuẩn lạc và không nhiều hơn 300 khuẩn lạc theo TCVN 4884: 2005;
+ 0,1 là thể tích mẫu cấy trên mỗi đĩa Petri, tính bằng mililit (ml);
+ n1 là số đĩa Petri được giữ lại ở độ pha loãng thứ nhất;
+ n2 là số đĩa Petri được giữ lại ở độ pha loãng thứ hai;
+ d là hệ số pha loãng tương ứng với độ pha loãng thứ nhất.
+ Làm tròn kết quả đến hai chữ số sau dấu phẩy;
► Biểu thị kết quả bằng cách lấy một trong các giá trị từ 1,0 đến 9,9 nhân với 10x, trong đó x là số mũ của 10.
a được xác định theo công thức (2):
|
| (2) |
► Trong đó
+ b là số lượng khuẩn lạc Streptomyces spp. giả định cho thấy có đặc điểm như phép thử khẳng định của tiêu chuẩn;
+ A là số lượng khuẩn lạc Streptomyces spp. giả định đã qua phép thử khẳng định;
+ C là tổng số khuẩn lạc Streptomyces spp. giả định đếm được trên đĩa Petri.
+ Làm tròn kết quả đến hai chữ số sau dấu phẩy.
10 Báo cáo thử nghiệm
Báo cáo thử nghiệm phải bao gồm ít nhất các thông tin sau:
a) mọi thông tin cần thiết để nhận biết đầy đủ mẫu thử;
b) phương pháp lấy mẫu đã sử dụng, nếu biết;
c) phương pháp thử nghiệm đã dùng hoặc viện dẫn tiêu chuẩn này;
d) mọi thao tác không được quy định trong tiêu chuẩn này, hoặc những điều được coi là tự chọn, và bất kỳ chi tiết nào có ảnh hưởng tới kết quả;
e) các kết quả thử nghiệm thu được.
PHỤ LỤC A: THÀNH PHẦN HOÁ CHẤT MÔI TRƯỜNG ISP4 VA GAUZE 1
(Quy định)
| Môi trường ISP4 |
| Môi trường Gauze 1 |
|
| Tinh bột (C6H10O5) | 10 g | Tinh bột tan | 20 g |
| K2HPO4 | 1 g | K2HPO4 | 0.5 g |
| MgSO4 .7H2O | 1 g | MgSO4 .7H2O | 0.5 g |
| NaCl | 1 g | KNO3 | 1 g |
| (NH4)2SO4 | 2 g | NaCl | 0.5 g |
| CaCO3 | 2 g | FeSO4. 7H2O | 0.01 vết |
| Dung dịch muối vi lượng | 1.0 ml | Nước cất bổ sung đạt thể tích | 1000 ml |
| Nước cất bổ sung đạt thể tích | 1000 ml | Agar | 20 g |
| Agar | 20 g | pH | 7.0 ± 0,2 |
| pH | 7.0 ± 0,2 |
|
|
PHỤ LỤC B: HÌNH THÁI ĐẶC TRƯNG CỦA Streptomyces spp. TRÊN MÔI TRƯỜNG ISP4 và Gauze 1
(Quy định)
Hình B.1. Khuẩn lạc Streptomyces spp.
PHỤ LỤC C: ĐẶC ĐIỂM BÀO TỬ Streptomyces spp. NUÔI CẤY TRÊN MÔI TRƯỜNG ISP4
(Quy định)
Quan sát hình thái tế bào dưới kính hiển vi quang học ở độ phóng đại 100 lần cho thấy chủng vi sinh vật sinh bào tử từ thành sợi khí sinh. Cuống sinh bào tử của Streptomyces spp. có dạng que ngắn, phân nhánh (ở một số loài khác thuộc chi Streptomyces cuống sinh bào tử có dạng que mảnh, xoắn, thẳng, uốn cong...). Đây là một đặc điểm quan trọng trong việc phân loại vi sinh vật ở mức độ tế bào (Theo khoá phân loại Bergey).

Hình C.1. Hình thái cuống sinh bào tử của Streptomyces spp. dưới kính hiển vi quang học ở độ phóng đại 100 lần
PHỤ LỤC D: TÁCH ADN VÀ QUY TRÌNH PHẢN ỨNG PCR
(Tham khảo)
(Theo phương pháp của Trần Nhân Dũng (2011) có bổ sung)
• Ly tâm dịch khuẩn với tốc độ 13000 vòng/phút trong 7 phút ở nhiệt độ phòng để thu cặn khuẩn. Lặp lại 2 lần.
• Hòa tan cặn khuẩn trong 600 μl đệm TE. Đánh tan cặn.
• Bổ sung 15 μl lysozyme 100 mg/ml
• Ủ ở 37 °C trong 1h
• Bổ sung 40 μl SDS 10 %. Trộn đều
• Bổ sung 8 μl proteinaise K (20 mg/ml). Trộn đều
• Ủ ở 56 °C trong 30 phút
• Tiếp tục bổ sung thêm 100 μl CTAB/NaCl. Trộn đều
• Bổ sung 100 μl NaCl 5M. Trộn đều
• Ủ ở 65 °C trong 10 phút
• Bổ sung 650 μl hỗn hợp phenol/Cloroform/isoamylalcohol (25:24:1) (đảo nhẹ nhàng), sau đó ly tâm 12000 vòng/phút trong 10 phút. Hút dịch nổi ở trên sang một ống mới. Lặp lại bước này 2 lần
• Bổ sung 500 μl isopropanol để kết tủa ADN. Đảo ống và ủ ở -20 °C trong 1 giờ. Sau đó
• Ly tâm với tốc độ 12000 r/min trong 15 phút ở 4 °C, loại dịch
• Rửa tủa bằng 500 μl ethanol 70% và ly tâm với tốc độ 12000 r/min trong 15 phút ở 4 QC.
• Loại bỏ dịch nổi phía trên và để khô. Hòa phần tủa khô với 20 - 30 μl dung dịch TE/nước cất vô trùng.
• ADN được đo nồng độ và độ tinh sạch bằng máy NanoDrop Lite Spectrophotome. Nồng độ ADN thu được cần đạt tối thiểu là 50 ng/1 μl , giá trị A260/280 ≥ 1,8, A260/230 tốt nhất trong khoảng từ 2,0 đến 2,2. Kiểm tra bằng điện di trên agarose 1% và bảo quản ở -20 °C (Hình 2). Nếu nồng độ ADN thu được nhỏ hơn 50 ng trong 1 μl dịch ADN thì có thể tăng lượng sản phẩm ban đầu đưa vào tách chiết ADN để thu được lượng ADN cao hơn.
• Thành phần phản ứng khuếch đại vùng 16S rRNA
|
| Thể tích |
| ADN (5 ng/μl) | 1 μl |
| Mồi xuôi 1 μM | 1 μl |
| Mồi ngược 1 μM | 1 μl |
| 2X Master Mix | 11 μl |
| Nước cất | 11 μl |
| Tổng | 25 μl |
• Quy trình luôn phải thực hiện song song mẫu thử nghiệm với mẫu đối chứng âm không chứa ADN khuôn và đối chứng dương (+) chứa ADN của chủng chuẩn.
• Đoạn gen 16S rRNA được khuếch đại PCR đơn chủng (khoảng 1500bp), sau đó được kiểm tra bằng điện di trên gel agarose 1%.
• Sản phẩm PCR sẽ được tinh sạch bằng bộ kít thương mại. Quá trình thực hiện theo hướng dẫn của nhà sản xuất với các bước cơ bản như sau: Đầu tiên bổ sung biding buffer với tỷ lệ 1:1 (v/v) với sản phẩm PCR và trộn đều, sau đó cho hỗn hợp lên cột tinh sạch. Ly tâm 13000 rpm trong 1 phút và loại bỏ dịch ly tâm. Bổ sung 700 μl EtOH 70 % vào cột tinh sạch và ly tâm 13000 r/min trong 1 phút, loại bỏ dịch ly tâm. Sau đó ly tâm cột tinh sạch 13000 r/min trong 1 phút để loại bỏ hết ethanol 70%. Chuyển cột tinh sạch sang ống Eppendorft 1.5 ml khử trùng và bổ sung 50 μl nước deion khử trùng. Ly tâm thu dịch DNA ở 13000 r/min trong 1 phút và điện di kiểm tra sản phẩm tinh sạch.
• Sản phẩm đạt yêu cầu sau khi kiểm tra được giải trình tự gene 16S rRNA. Dữ liệu giải trình tự sau đó được phân tích bằng phần mềm Chromas phiên bản 2.4. Trình tự tinh chỉnh của từng phân đoạn được so sánh với trình tự 16S rRNA của các loài tương tự đã được công bố trong cơ sở dữ liệu của trình tự GenBank bằng công cụ tìm kiếm BLAST cho thấy, trình tự đoạn gen 16S rRNA của Streptomyces spp. giả định có độ tương đồng cao nhất với loài Streptomyces sp là 98,88% (OR145798.1).
• Đoạn gen 16S rRNA của Streptomyces spp. giả định có giá trị tương đồng ≥ 98 % với đoạn gen 16S rRNA của chi Streptomyces được coi là ngưỡng để khẳng định đến loài.

| Hình D.1. ADN tổng số của Streptomyces spp. | Hình D.2. Sản phẩm PCR đoạn gen 16S rRNA được tinh sạch của Streptomyces spp. |

Hình D.3. Kết quả so sánh độ tương đồng trình tự gen 16S rRNA của chủng xạ khuẩn Streptomyces spp. giả định với trình tự gen 16S rRNA của chủng xạ khuẩn trên GenBank bằng ứng dụng Nucleotid Blast

Hình D.4. Kết quả so sánh độ tương đồng trình tự gen 16S rRNA của chủng xạ khuẩn Streptomyces lydicus (NBRC 13058) (ĐC+) với trình tự gen 16S rRNA của chủng xạ khuẩn trên GenBank bằng ứng dụng Nucleotid Blast
THƯ MỤC TÀI LIỆU THAM KHẢO
[1] Weisberg WG, Bams SM, Pelletier DA, Lane DJ.1991. 16S ribosomal DNA amplification for phylogenetic study. J Bacteriol 173: 697-703.
[2] TCVN 7715-2:2007 (ISO 10272-2: 2006) về Vi sinh vật trong thực phẩm và thức ăn chăn nuôi - Phương pháp phát hiện và định lượng Campylobacter spp - Phần 2: Kỹ thuật đếm khuẩn lạc.
[3] TCVN 1-2 : 2008. Xây dựng tiêu chuẩn - Phần 2: Quy định về trình bày và thể hiện nội dung tiêu chuẩn quốc gia
[4] TCVN 11133:2015 (ISO 22119:2011), Vi sinh vật trong thực phẩm, thức ăn chăn nuôi - Phản ứng chuỗi polymerase real-time (per real-time) để phát hiện vi sinh vật gây bệnh từ thực phẩm - Định nghĩa và yêu cầu chung Vi sinh vật trong thực phẩm, thức ăn chăn nuôi.
[5] Stanley T, Williams MG, Sharpe JG (1989). Bergey’s manual of systematic bacteriology. Williams and Wilkins 4: 2452-2492.
[6] Jaekyeong Song, Seong-Chan Lee, Jun-Won Kang, Hyung-Jin Baek and Joo-Won Suh (2004). Phylogenetic analysis of Streptomyces spp. isolated from potato scab lesions in Korea on the basis of 16S rRNA gene and 16S-23S rDNA internally transcribed spacer sequences International Journal of Systematic and Evolutionary Microbiology., 54: 203-209.
[7] Trần Nhân Dũng (2011). Sổ tay thực hành sinh học phân tử. Nhà xuất bản Đại học Cần Thơ, 175 trang.
[8] Mohamed E. Hamid, Adil Mahgoub, Abdulrhman J. O. Babiker, Hussein A. E. Babiker, Mohammed A. I. Holie, Mogahid M. Elhassan and Martin R. P. Joseph (2020). Isolation and Identification of Streptomyces spp. from Desert and Savanna Soils in Sudan. Int. J. Environ. Res. Public Health., 17, 8749; doi:10.3390/ijerph17238749
[9] Nawan, Septi. Handayani 2021. Molecular identification of Streptomyces sp. isolated from peat land of Palangka Raya, Kalimantan Tengah using 16S rRNA gene sequences analysis. Research Journal of Pharmacy and Technology.; 14(12):6639-4. doi: 10.52711/0974-360X.2021.01147
Bạn chưa Đăng nhập thành viên.
Đây là tiện ích dành cho tài khoản thành viên. Vui lòng Đăng nhập để xem chi tiết. Nếu chưa có tài khoản, vui lòng Đăng ký tại đây!
